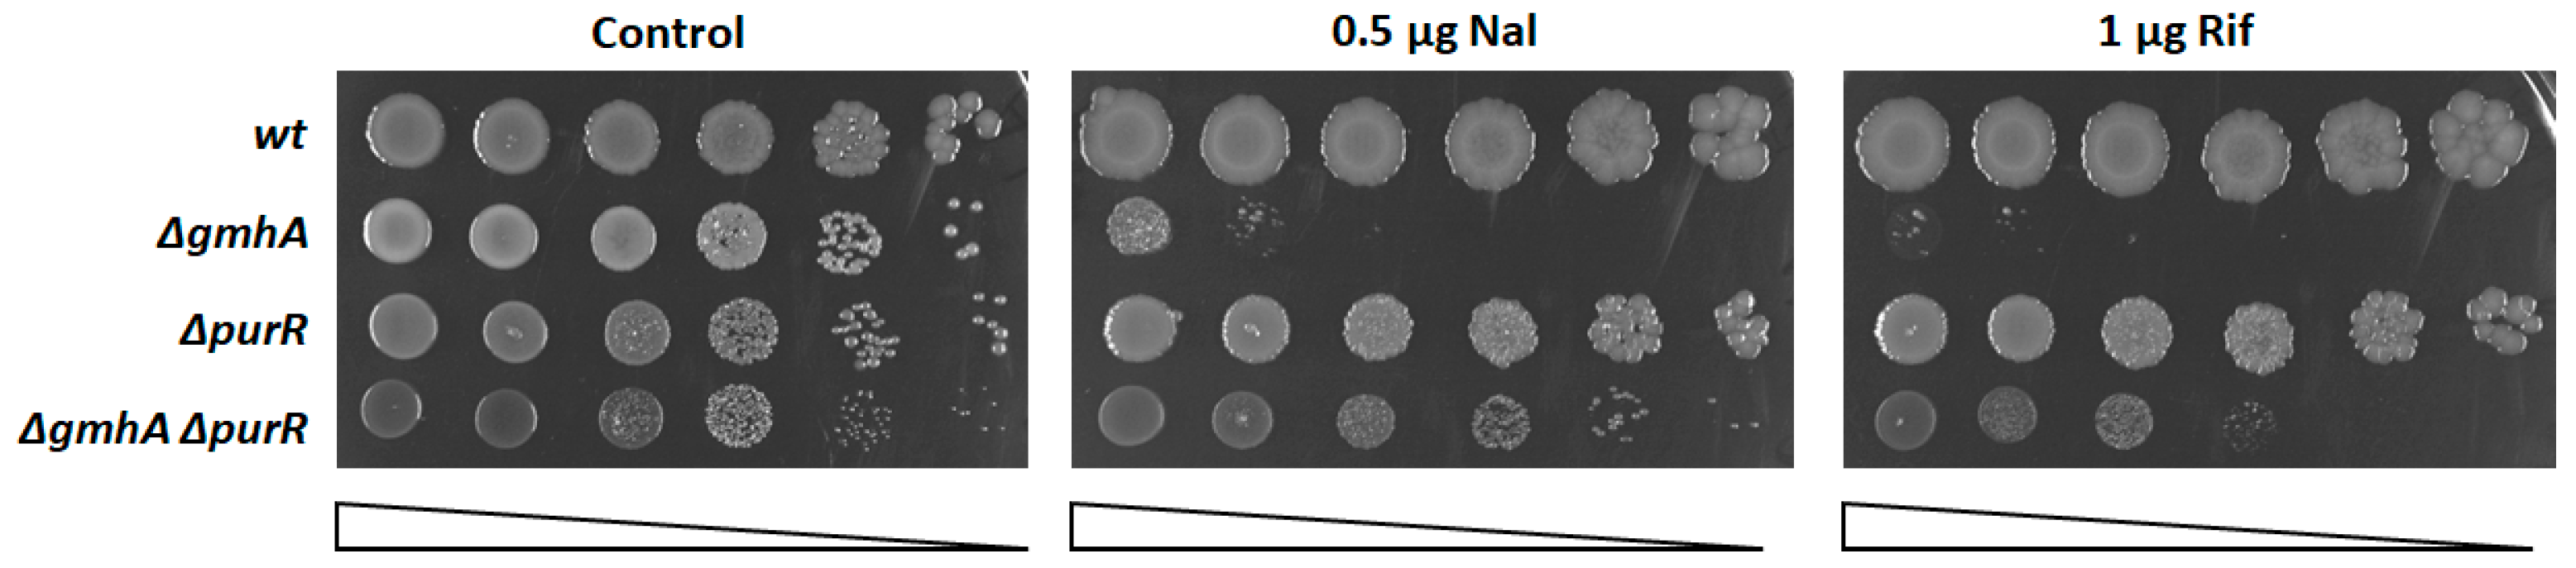

Activation of Purine Biosynthesis Suppresses the Sensitivity of E. coli gmhA Mutant to Antibiotics
Abstract
:1. Introduction
2. Results
2.1. Derepression of Purine Synthesis Suppresses the Sensitivity of the gmhA Mutant to Antibiotics Subsection
2.2. Suppression of Oxidative Stress
2.3. Oxidative Modification of Protein Thiol Groups
2.4. Glutathionylation of Proteins in the ΔgmhA Mutant
3. Discussion
4. Materials and Methods
Statistical Analysis
Author Contributions
Funding
Institutional Review Board Statement
Informed Consent Statement
Data Availability Statement
Conflicts of Interest
References
- Karan, S.; Pratap, B.; Yadav, S.P.; Ashish, F.; Saxena, A.K. Structural and Functional Characterization of M. Tuberculosis Sedoheptulose- 7-Phosphate Isomerase, a Critical Enzyme Involved in Lipopolysaccharide Biosynthetic Pathway. Sci. Rep. 2020, 10, 20813. [Google Scholar] [CrossRef]
- Taylor, P.L.; Blakely, K.M.; de Leon, G.P.; Walker, J.R.; McArthur, F.; Evdokimova, E.; Zhang, K.; Valvano, M.A.; Wright, G.D.; Junop, M.S. Structure and Function of Sedoheptulose-7-Phosphate Isomerase, a Critical Enzyme for Lipopolysaccharide Biosynthesis and a Target for Antibiotic Adjuvants. J. Biol. Chem. 2008, 283, 2835–2845. [Google Scholar] [CrossRef]
- Seregina, T.A.; Petrushanko, I.Y.; Shakulov, R.S.; Zaripov, P.I.; Makarov, A.A.; Mitkevich, V.A.; Mironov, A.S. The Inactivation of LPS Biosynthesis Genes in E. coli Cells Leads to Oxidative Stress. Cells 2022, 11, 2667. [Google Scholar] [CrossRef]
- Konstantin, S.; Elena, S.; Alexander, M. Nudler Evgeny H2S: A Universal Defense Against Antibiotics in Bacteria. Science 2011, 334, 986–990. [Google Scholar] [CrossRef]
- Mironov, A.; Seregina, T.; Nagornykh, M.; Luhachack, L.G.; Korolkova, N.; Lopes, L.E.; Kotova, V.; Zavilgelsky, G.; Shakulov, R.; Shatalin, K.; et al. Mechanism of H2S-Mediated Protection against Oxidative Stress in Escherichia coli. Proc. Natl. Acad. Sci. USA 2017, 114, 6022–6027. [Google Scholar] [CrossRef]
- Mironov, A.; Seregina, T.; Shatalin, K.; Nagornykh, M.; Shakulov, R.; Nudler, E. CydDC Functions as a Cytoplasmic Cystine Reductase to Sensitize Escherichia coli to Oxidative Stress and Aminoglycosides. Proc. Natl. Acad. Sci. USA 2020, 117, 23565–53570. [Google Scholar] [CrossRef]
- De Leon, G.P.; Elowe, N.H.; Koteva, K.P.; Valvano, M.A.; Wright, G.D. An In Vitro Screen of Bacterial Lipopolysaccharide Biosynthetic Enzymes Identifies an Inhibitor of ADP-Heptose Biosynthesis. Chem. Biol. 2006, 13, 437–441. [Google Scholar] [CrossRef]
- Moreau, F.; Desroy, N.; Genevard, J.M.; Vongsouthi, V.; Gerusz, V.; Le Fralliec, G.; Oliveira, C.; Floquet, S.; Denis, A.; Escaich, S.; et al. Discovery of New Gram-Negative Antivirulence Drugs: Structure and Properties of Novel E. coli WaaC Inhibitors. Bioorganic Med. Chem. Lett. 2008, 18, 4022–4026. [Google Scholar] [CrossRef]
- Desroy, N.; Denis, A.; Oliveira, C.; Atamanyuk, D.; Briet, S.; Faivre, F.; LeFralliec, G.; Bonvin, Y.; Oxoby, M.; Escaich, S.; et al. Novel HldE-K Inhibitors Leading to Attenuated Gram Negative Bacterial Virulence. J. Med. Chem. 2013, 56, 1418–1430. [Google Scholar] [CrossRef]
- Stincone, A.; Prigione, A.; Cramer, T.; Wamelink, M.M.C.; Campbell, K.; Cheung, E.; Olin-Sandoval, V.; Grüning, N.-M.; Krüger, A.; Tauqeer Alam, M.; et al. The Return of Metabolism: Biochemistry and Physiology of the Pentose Phosphate Pathway. Biol. Rev. 2015, 90, 927–963. [Google Scholar] [CrossRef]
- Krüger, A.; Grüning, N.-M.; Wamelink, M.M.C.; Kerick, M.; Kirpy, A.; Parkhomchuk, D.; Bluemlein, K.; Schweiger, M.-R.; Soldatov, A.; Lehrach, H.; et al. The Pentose Phosphate Pathway Is a Metabolic Redox Sensor and Regulates Transcription During the Antioxidant Response. Antioxid. Redox Signal. 2011, 15, 311–324. [Google Scholar] [CrossRef]
- He, B.; Shiau, A.; Choi, K.Y.; Zalkin, H.; Smith, J.M. Genes of the Escherichia coli Pur Regulon Are Negatively Controlled by a Repressor-Operator Interaction. J. Bacteriol. 1990, 172, 4555–4562. [Google Scholar] [CrossRef]
- Amábile-Cuevas, C.F.; Demple, B. Molecular Characterization of the soxRS Genes of Escherichia coli: Two Genes Control a Superoxide Stress Regulon. Nucleic Acids Res. 1991, 19, 4479–4484. [Google Scholar] [CrossRef]
- Wrona, M.; Patel, K.; Wardman, P. Reactivity of 2′,7′-Dichlorodihydrofluorescein and Dihydrorhodamine 123 and Their Oxidized Forms toward Carbonate, Nitrogen Dioxide, and Hydroxyl Radicals. Free. Radic. Biol. Med. 2005, 38, 262–270. [Google Scholar] [CrossRef]
- Shams, F.; Oldfield, N.; Wooldridge, K.; Turner, D. Fructose-1,6-Bisphosphate Aldolase (FBA)-A Conserved Glycolytic Enzyme with Virulence Functions in Bacteria: “Ill Met by Moonlight”. Biochem. Soc. Trans. 2014, 42, 1792–1795. [Google Scholar] [CrossRef]
- Matsumoto, M.; Ogawa, K. New Insight into the Calvin Cycle Regulation—Glutathionylation of Fructose Bisphosphate Aldolase in Response to Illumination. In Photosynthesis. Energy from the Sun; Allen, J.F., Gantt, E., Golbeck, J.H., Osmond, B., Eds.; Springer: Dordrecht, The Netherlands, 2008; pp. 871–874. [Google Scholar]
- Krapp, A.R.; Humbert, M.V.; Carrillo, N. The soxRS Response of Escherichia coli Can Be Induced in the Absence of Oxidative Stress and Oxygen by Modulation of NADPH Content. Microbiology 2011, 157 Pt 4, 957–965. [Google Scholar] [CrossRef]
- Xiong, Y.; Uys, J.D.; Tew, K.D.; Townsend, D.M. S-Glutathionylation: From Molecular Mechanisms to Health Outcomes. Antioxid. Redox Signal. 2011, 15, 233–270. [Google Scholar] [CrossRef]
- McDonagh, B.; Pedrajas, J.R.; Padilla, C.A.; Bárcena, J.A. Thiol Redox Sensitivity of Two Key Enzymes of Heme Biosynthesis and Pentose Phosphate Pathways: Uroporphyrinogen Decarboxylase and Transketolase. Oxidative Med. Cell. Longev. 2013, 2013, 932472. [Google Scholar] [CrossRef]
- Baba, T.; Ara, T.; Hasegawa, M.; Takai, Y.; Okumura, Y.; Baba, M.; Datsenko, K.A.; Tomita, M.; Wanner, B.L.; Mori, H. Construction of Escherichia coli K-12 in-Frame, Single-Gene Knockout Mutants: The Keio Collection. Mol. Syst. Biol. 2006, 2, 2006.0008. [Google Scholar] [CrossRef]
- Datsenko Kirill, A.; Wanner Barry, L. One-Step Inactivation of Chromosomal Genes in Escherichia coli K-12 Using PCR Products. Proc. Natl. Acad. Sci. USA 2000, 97, 6640–6645. [Google Scholar] [CrossRef]
- Kotova, V.Y.; Manukhov, I.V.; Zavilgelskii, G.B. Lux-Biosensors for Detection of SOS-Response, Heat Shock, and Oxidative Stress. Appl. Biochem. Microbiol. 2010, 46, 781–788. [Google Scholar] [CrossRef]
- Rahman, I.; Kode, A.; Biswas, S.K. Assay for Quantitative Determination of Glutathione and Glutathione Disulfide Levels Using Enzymatic Recycling Method. Nat. Protoc. 2006, 1, 3159–3165. [Google Scholar] [CrossRef]

| Strain | Genotype | Origin |
|---|---|---|
| MG1655 | F– wild type | [4] |
| ∆gmhA | Deletion of the gmhA D-sedoheptulose 7-phosphate isomerase | [3] |
| ∆purR | Deletion of the DNA-binding transcriptional repressor PurR | This work |
| ∆gmhA ∆purR | Deletion of the gmhA D-sedoheptulose 7-phosphate isomerase and deletion of the DNA-binding transcriptional repressor PurR | This work |
| ∆gmhA ∆purR ∆purF | Deletion of the gmhA D-sedoheptulose 7-phosphate isomerase, deletion of the DNA-binding transcriptional repressor PurR and deletion of the amidophosphoribosyltransferase | This work |
| ∆gmhA ∆purR ∆purH | Deletion of the gmhA D-sedoheptulose 7-phosphate isomerase, deletion of the DNA-binding transcriptional repressor PurR and deletion of the bifunctional AICAR transformylase/IMP cyclohydrolase | This work |
| ∆fbaB | Deletion of the fructose-bisphosphate aldolase class I | This work |
| ∆gmhA ∆fbaB | Deletion of the gmhA D-sedoheptulose 7-phosphate isomerase and deletion of the fructose-bisphosphate aldolase class I | This work |
| MG1655 pSoxS::lux | As MG1655, plus pSox::lux plasmid | This work |
| ∆gmhA pSoxS::lux | As ∆gmhA, plus pSox::lux plasmid | This work |
| ∆purR pSoxS::lux | As ∆purR, plus pSox::lux plasmid | This work |
| ∆gmhA ∆purR pSoxS::lux | As ∆gmhA ∆purR, plus pSox::lux plasmid | This work |
Disclaimer/Publisher’s Note: The statements, opinions and data contained in all publications are solely those of the individual author(s) and contributor(s) and not of MDPI and/or the editor(s). MDPI and/or the editor(s) disclaim responsibility for any injury to people or property resulting from any ideas, methods, instructions or products referred to in the content. |
© 2023 by the authors. Licensee MDPI, Basel, Switzerland. This article is an open access article distributed under the terms and conditions of the Creative Commons Attribution (CC BY) license (https://creativecommons.org/licenses/by/4.0/).
Share and Cite
Seregina, T.A.; Petrushanko, I.Y.; Zaripov, P.I.; Shakulov, R.S.; A. Sklyarova, S.; Mitkevich, V.A.; Makarov, A.A.; Mironov, A.S. Activation of Purine Biosynthesis Suppresses the Sensitivity of E. coli gmhA Mutant to Antibiotics. Int. J. Mol. Sci. 2023, 24, 16070. https://doi.org/10.3390/ijms242216070
Seregina TA, Petrushanko IY, Zaripov PI, Shakulov RS, A. Sklyarova S, Mitkevich VA, Makarov AA, Mironov AS. Activation of Purine Biosynthesis Suppresses the Sensitivity of E. coli gmhA Mutant to Antibiotics. International Journal of Molecular Sciences. 2023; 24(22):16070. https://doi.org/10.3390/ijms242216070
Chicago/Turabian StyleSeregina, Tatiana A., Irina Yu. Petrushanko, Pavel I. Zaripov, Rustem S. Shakulov, Svetlana A. Sklyarova, Vladimir A. Mitkevich, Alexander A. Makarov, and Alexander S. Mironov. 2023. "Activation of Purine Biosynthesis Suppresses the Sensitivity of E. coli gmhA Mutant to Antibiotics" International Journal of Molecular Sciences 24, no. 22: 16070. https://doi.org/10.3390/ijms242216070
APA StyleSeregina, T. A., Petrushanko, I. Y., Zaripov, P. I., Shakulov, R. S., A. Sklyarova, S., Mitkevich, V. A., Makarov, A. A., & Mironov, A. S. (2023). Activation of Purine Biosynthesis Suppresses the Sensitivity of E. coli gmhA Mutant to Antibiotics. International Journal of Molecular Sciences, 24(22), 16070. https://doi.org/10.3390/ijms242216070

